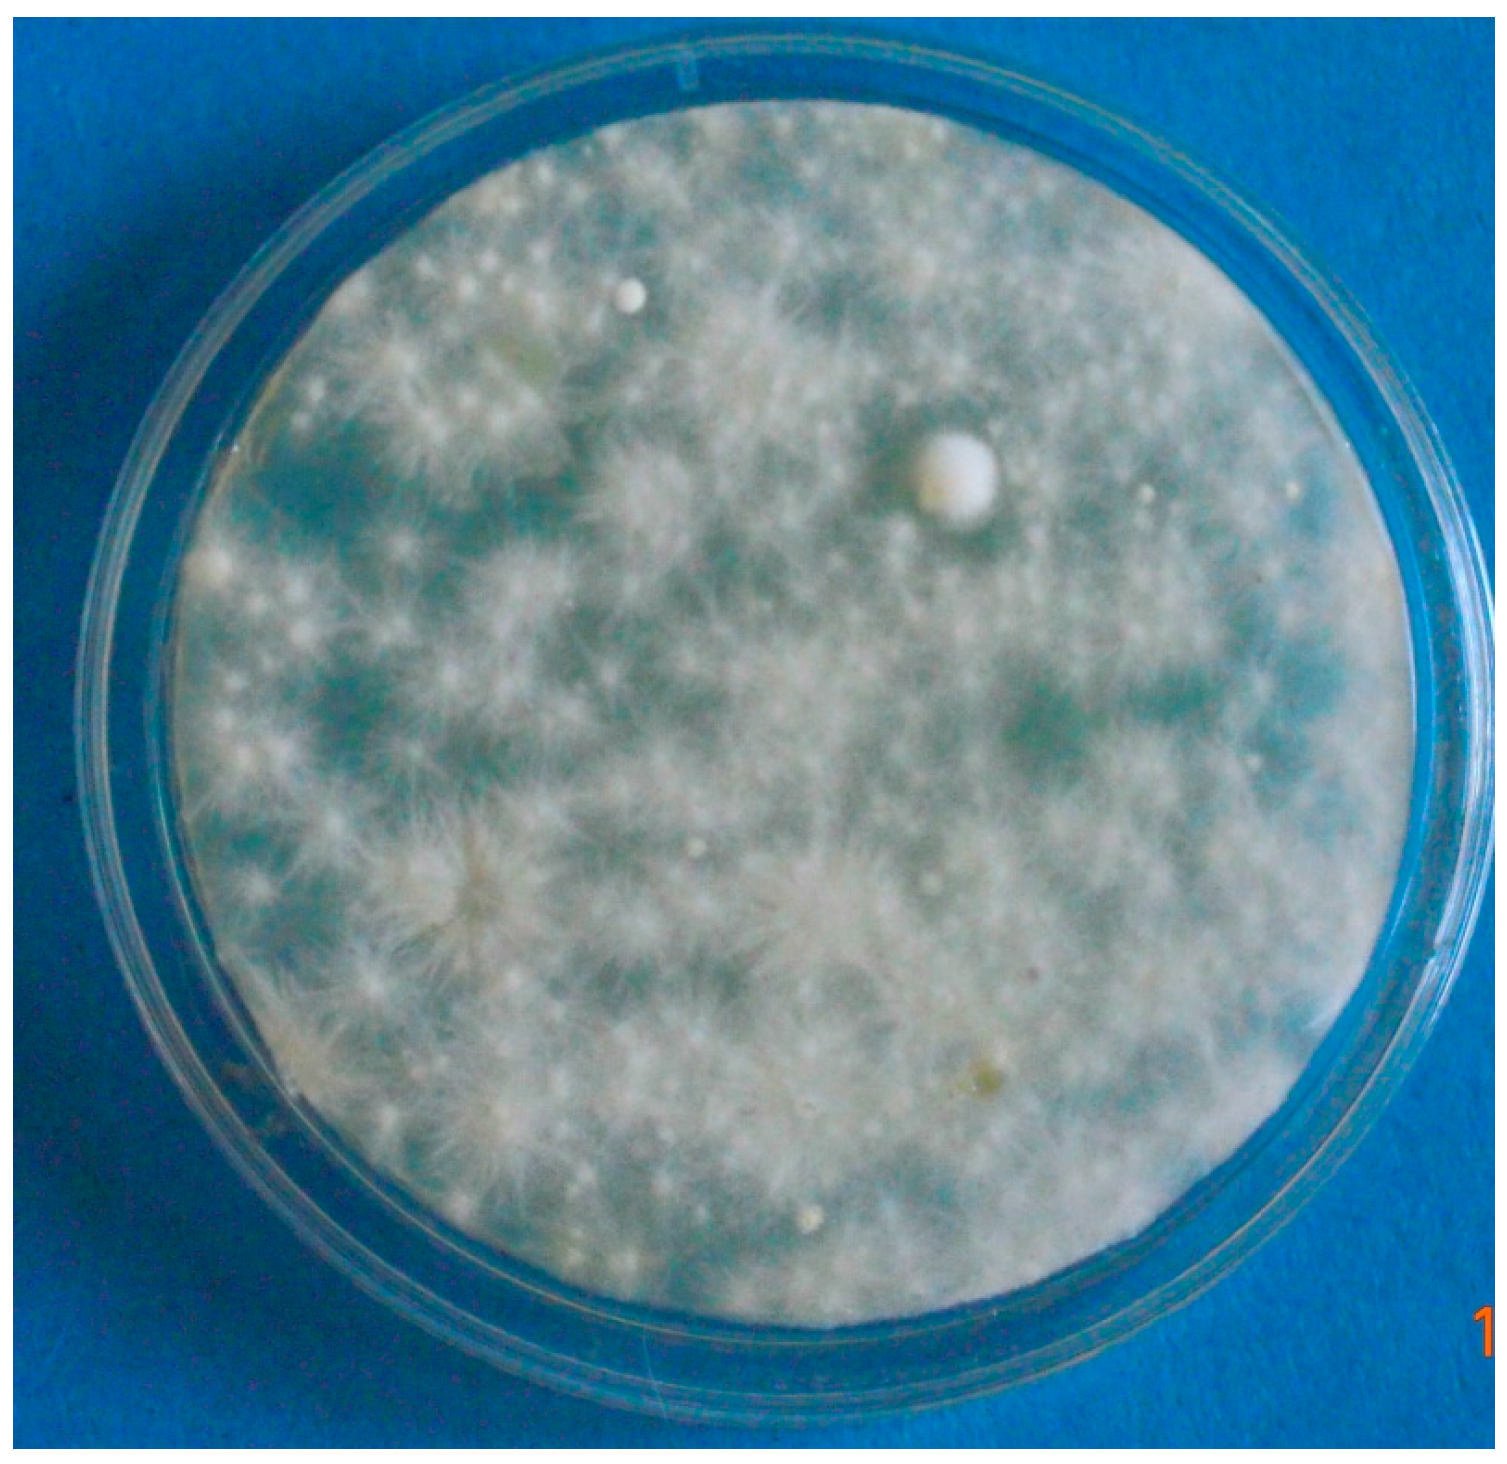
Vetsci 04 00046 g004

Infection by Microsporum canis in Paediatric Patients: A Veterinary Perspective
Abstract
1. Introduction
2. Materials and Methods
3. Results
3.1. Case 1 (April, 2014)
3.2. Case 2 (March, 2016)
3.3. Case 3 (May, 2017)
4. Discussion
5. Conclusions
Author Contributions
Conflicts of Interest
References
- Weitzman, I.; Summerbell, R.C. The dermatophytes. Clin. Microbiol. Rev. 1995, 8, 240–259. [Google Scholar] [CrossRef]
- Chermette, R.; Ferreiro, L.; Guillot, J. Dermatophytoses in Animals. Mycopathologia 2008, 166, 385–405. [Google Scholar] [CrossRef] [PubMed]
- Gallo, M.G.; Tizzani, P.; Peano, A.; Rambozzi, L.; Meneguz, P.G. Eastern cottontail (Sylvilagus floridanus) as carrier of dermatophyte fungi. Mycopathologia 2005, 160, 163–166. [Google Scholar] [CrossRef] [PubMed]
- Gallo, M.G.; Lanfranchi, P.; Poglayen, G.; Calderola, S.; Menzano, A.; Ferroglio, E.; Peano, A. Seasonal 4-year investigation into the role of the alpine marmot (Marmota marmota) as a carrier of zoophilic dermatophytes. Med. Mycol. 2005, 43, 373–379. [Google Scholar] [CrossRef] [PubMed]
- Pal, M.; Dave, P. Tinea faciei in a goat handler due to Microsporum canis. Rev. Iberoam. Micol. 2005, 22, 181–182. [Google Scholar] [CrossRef]
- Moriello, K.A. Diagnostic techniques for dermatophytosis. Clin. Tech. Small Anim. Pract. 2001, 16, 219–224. [Google Scholar] [CrossRef] [PubMed]
- Ginter-Hanselmayer, G.; Weger, W.; Ilkit, M.; Smolle, J. Epidemiology of tinea capitis in Europe: Current state and changing patterns. Mycoses 2007, 50, 6–13. [Google Scholar] [CrossRef] [PubMed]
- Seebacher, C.; Bouchara, J.-P.; Mignon, B. Updates on the epidemiology of dermatophyte infections. Mycopathologia 2008, 166, 335–352. [Google Scholar] [CrossRef] [PubMed]
- Alteras, I.; Feuerman, E.J. Two outbreaks of Microsporum canis ringworm in Israel. Mycopathologia 1979, 67, 169–172. [Google Scholar] [CrossRef] [PubMed]
- Lawson, G.T.; McLeod, W.J. Microsporum canis; an intensive outbreak. Br. Med. J. 1957, 2, 1159–1160. [Google Scholar] [CrossRef] [PubMed]
- Preiser, G. An outbreak of Tinea Corporis among schoolgirls. Pediatrics 1991, 88, 327–328. [Google Scholar] [PubMed]
- Subelj, M.; Marinko, J.S.; Učakar, V. An outbreak of Microsporum canis in two elementary schools in a rural area around the capital city of Slovenia, 2012. Epidemiol. Infect. 2014, 142, 2662–2666. [Google Scholar] [CrossRef] [PubMed]
- Moriello, K.A.; Coyner, K.; Paterson, S.; Mignon, B. Diagnosis and treatment of dermatophytosis in dogs and cats. Clinical Consensus Guidelines of the World Association for Veterinary Dermatology. Vet. Dermatol. 2017, 28, 266–268. [Google Scholar] [CrossRef] [PubMed]
- ESCCAP (European Scientific Counsel Companion Animal Parasites). Guideline 2: Superficial Mycoses in Dogs and Cats. Available online: http://www.esccap.org/uploads/docs/uh82a6e8_esccapgl2guidelines.pdf (accessed on 15 July 2017).
- Snider, R.; Landers, S.; Levy, M.L. The ringworm riddle: An outbreak of Microsporum canis in the nursery. Pediatr. Infect. Dis. J. 1993, 12, 145–148. [Google Scholar] [CrossRef] [PubMed]

© 2017 by the authors. Licensee MDPI, Basel, Switzerland. This article is an open access article distributed under the terms and conditions of the Creative Commons Attribution (CC BY) license (http://creativecommons.org/licenses/by/4.0/).
Share and Cite
Pasquetti, M.; Min, A.R.M.; Scacchetti, S.; Dogliero, A.; Peano, A. Infection by Microsporum canis in Paediatric Patients: A Veterinary Perspective. Vet. Sci. 2017, 4, 46. https://doi.org/10.3390/vetsci4030046
Pasquetti M, Min ARM, Scacchetti S, Dogliero A, Peano A. Infection by Microsporum canis in Paediatric Patients: A Veterinary Perspective. Veterinary Sciences. 2017; 4(3):46. https://doi.org/10.3390/vetsci4030046
Chicago/Turabian StylePasquetti, Mario, Anna Rita Molinar Min, Stefania Scacchetti, Andrea Dogliero, and Andrea Peano. 2017. "Infection by Microsporum canis in Paediatric Patients: A Veterinary Perspective" Veterinary Sciences 4, no. 3: 46. https://doi.org/10.3390/vetsci4030046
APA StylePasquetti, M., Min, A. R. M., Scacchetti, S., Dogliero, A., & Peano, A. (2017). Infection by Microsporum canis in Paediatric Patients: A Veterinary Perspective. Veterinary Sciences, 4(3), 46. https://doi.org/10.3390/vetsci4030046

